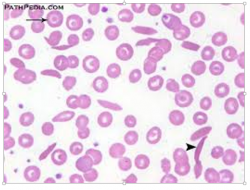

המוגלובין - Hemoglobin - S
| מדריך בדיקות מעבדה | |
| המוגלובין S | |
|---|---|
| Hemoglobin S | |
| שמות אחרים | Hemoglobin S ,Sickledex ,Sickle Cell Screen |
| |
תמונה אופיינית של משטח דם במקרה של אנמיה חרמשית המתבטאת בתאי-דם מאורכים דמויי-כישור
| |
| מעבדה | המטולוגיה בדם |
| תחום | פיענוח מפגע של אנמיה חרמשית |
| טווח ערכים תקין | אלקטרופורזה של Hb משמשת כמבחן סריקה לזיהוי וריאנטים וצורות Hb לא תקינות, כולל HbF ,HbA2 ,HbA1 (המוגלובין עוברי), HbC ו-HbS. ערכי הייחוס הם (ע"פ Ferri ב-Ferri's clinical advisor : instant diagnosis and treatment. St. Louis: Mosby; 2012) HbA 1: 95%-98% ; HbA2: 1.5-3.5%;) HbF: <2% בתלות בגיל); HbC -אין; HbS-אין. |
| יוצר הערך | פרופ' בן-עמי סלע |
לערכים נוספים הקשורים לנושא זה, ראו את דף הפירושים – המוגלובינופתיות
המוגלובין
המוגלובין (להלן Hb) הוא מטאלו-פרואטין המכיל ברזל המשמש לטרנספורט של חמצן תאי דם אדומים של כל בעלי החוליות פרט למשפחת דגים מסוג Channichthvidae (ע"פ Sidell ו-O'brien ב-J Exp Biol משנת 2006), כמו גם ברקמות של מספר חסרי-חוליות. המוגלובין בדם נושא חמצן ממערכת הנשימה (ריאות וזימים) לכל רקמות הגוף, שם הוא משחרר את מטען החמצן כדי לאפשר נשימה אירובית, לאספקת אנרגיה הנדרשת לתהליכים מטבוליים בגוף. ביונקים, המוגלובין מהווה עד 96% מהתכולה היבשה של אריתרוציטים על בסיס משקל, ובערך 35% של סך משקל האריתרוציט (כולל מים) (Weed וחב' ב-J Clin Invest משנת 1963). להמוגלובין יכולת קישור חמצן של 1.34 מיליליטר חמצן לגר' המוגלובין (ע"פ Dominguez de Villota וחב' ב- Br J Anaesthel משנת 2001), מה שמגדיל את סך היכולת של קישור חמצן פי-70 בהשוואה לחמצן הנישא בדם כחלבון מסיס. מולקולת המוגלובין יכולה לקשור ולשאת עד 4 מולקולות חמצן.
המוגלובין כרוך גם בטרנספורט של גזים אחרים: הוא נושא כ-20-25% מדו-תחמוצת הפחמן בצורת carbaminohemoglobin, בו CO2 קשור לחלבון גלובין. המוגלובין נושא גם את המולקולה מרחיבת כלי הדם NO הנקשרת לשייר thiol של החלבון גלובין, ומשחרר את NO ביחד עם השחרור של חמצן (Epstein ו-Hsia ב-N Eng J Med משנת 1998). המוגלובין מקנה לאריתרוציטים את צבעם האדום.
המוגלובין נמצא גם מחוץ לתאי הדם האדומים, כאשר תאים אחרים המכילים Hb הם נוירונים דופמינרגיים מסוג A9 הנמצאים ב-substantia nigra, וכן במקרופאגים, בתאים אלבאולריים, ובתאים מזגנגיאליים בכליות. ברקמות אלו, המוגלובין הוא בעל תפקיד של נוגד-חמצון ומווסת של מטבוליזם של ברזל, ולא בהכרח תפקיד של נשיאת חמצן (Biagioli וחב' ב-Proc Natl Acad Sci USA משנת 2009).
היבטים היסטוריים בגילוי המוגלובין
בשנת 1825 גילה Engelhard שהיחס בין Fe לחלבון זהה בהמוגלובינים של מינים שונים, ומידיעת המסה האטומית של ברזל הוא חישב את המשקל המולקולארי של מסת המוגלובין כ-nX16,000, כאשר n הוא מספר אטומי הברזל למולקולת המוגלובין, שכיום ידוע כ-4. הייתה זו הקביעה הראשונה של המסה המולקולארית של המוגלובין. מסקנה "פזיזה" זו של Engelhard גרמה להרבה חיצי ביקורת ולעג לעברו מצד חוקרי התקופה, שהתקשו אז להאמין ש"מולקולת חלבון יכולה להיות כה גדולה". חלפו בדיוק 100 שנים עד ש-Adair אישר בשנת 1925 את ההערכה המוקדמת של Engelhard על ידי מדידת הלחץ האוסמוטי של תמיסות המוגלובין במחקר שפרסם ב-Proc Royal Soc Lond.
למעשה הראשון שגילה את החלבון נושא החמצן המוגלובין בתור שכזה, היה הכימאי הגרמני Hünefeld מ-Leipzig בשנת 1840. הפיזיולוג הגרמני Otto Funke פרסם בשנת 1851 בכתב העת Ztschr.f. rat. Med סדרת מאמרים בהם הוא תאר יצירת גבישים הולכים וגדלים של המוגלובין על ידי מיהול הדרגתי של תאי דם אדומים במים מזוקקים, באלכוהול או באתר, שלאחריו הוא נידף באיטיות את הנוזל הממס המכיל את החלבון. ב-1866 היה זה הפיזיולוג הגרמני Hoppe-Seyler שתיאר את היכולת לחמצן באופן הפיך את החלבון המוגלובין בכתב העת Med-chem Untersuch Lab.
אך היה צורך להמתין כ-100 שנה עד למחקרו פורץ הדרך של הביוכימאי האנגלי Max Perutz שתיאר את המבנה המולקולארי של מיוגלובין (הדומה לזה של המוגלובין) בשיטת קריסטלוגרפיה של קרני X במאמר שפרסם ב-Nature בשנת 1960, הישג שזיכה אותו בשנת 1962 בפרס נובל בכימיה. תפקידו של המוגלובין בדם פוענח על ידי הפיזיולוג הצרפתי Claude Bernard.
סינתזה של המוגלובין
המוגלובין מסונתז במהלך של מספר שלבים מורכבים. גרעין ה-heme מסונתז במספר שלבים במיטוכונדריה ובציטוזול של אריתרוציטים לא בשלים ואילו החלבון גלובין מסונתז על ידי הריבוזומים בציטוזול (Burka ב-J Clin Invest משנת 1969). יצירת המוגלובין נמשכת לאורך שלבי ההתפתחות המוקדמים של האריתרוציט משלב ה-proerythroblast עד שלב הרטיקולוציט במח העצם. בשלב זה, גרעין התא נעלם באריתרוציטים של יונקים, אך לא בציפורים או במינים אחרים. אך אפילו לאחר היעלמות הגרעין, RNA ריבוזומאלי שארי, מאפשר סינתזה נוספת של המוגלובין עד שהרטיקולוציט מאבד את ה-RNA שלו מיד לאחר שתאים אלה נכנסים לצירקולציה.
היכולת האדפטיבית של המוגלובין
המוגלובין מורכב מתת יחידות חלבוניות הידועות כ"גלובינים". ישנו יותר מגן אחד המקודד להמוגלובין: באדם, hemoglobin A (שהיא צורת ההמוגלובין העיקרית) מקודדת על ידי הגנים HBA2, HBA1 ו-HBB (ע"פ Hardison ב-Cold Spring Harbor Perspectives in Medicine משנת 2012). רצף חומצות האמינו של חלבוני הגלובין שונה בין המינים השונים. לדוגמה, הרצפים השכיחים ביותר של חומצות האמינו באדם ובשימפנזה כמעט זהים, והם שונים ביניהם רק בחומצת אמינו אחת בשרשרות הגלובין אלפא ובטא, אך ההבדלים מהותיים יותר ככל שגדל המרחק בין המינים.
אפילו בתוך אותו מין, קיימים וריאנטים שונים של המוגלובין, למרות שרצף אחד הוא בדרך כלל השכיח ביותר באותו מין. מוטציות בגנים של המוגלובין יוצרות וריאנטים שונים של החלבון. רבות מהצורות המוטגניות של המוגלובין אינן גורמות לכל מחלה אך מיעוטן גורמות למחלות מורשות המכונות המוגלובינופתיות. המחלה הידועה ביותר הנגרמת ממוטציה בהמוגלובין היא אנמיה חרמשית (sickle cell disease), שהייתה גם המפגע הראשון שהמנגנון שלו הובן ברמה המולקולארית. מערכת שונה (לרוב) של מפגעי המוגלובין ידועים כ-"תלסמיות" הכרוכות ביצירה פחותה של המוגלובין או ביצירת המוגלובין פגום, כתוצאה ממוטציות בגנים המשפיעים על הרגולציה של גלובין. כל המפגעים הללו גורמים לאנמיה.
וריאציות ברצפי חומצות אמינו של המוגלובין, יכולים להיות "הסתגלותיים" (adaptive). לדוגמה, המוגלובין נמצא מסתגל בדרכים שונות להימצאות באזורים גיאוגרפיים גבוהים. יצורים המתגוררים דרך קבע באזורים הרריים גבוהים, נחשפים ללחצי חמצן נמוכים יותר, מאלה להם נחשפים אלה המתגוררים בגובה פני הים. עובדה זו מציגה אתגר שכן המוגלובין קושר חמצן בלחץ חלקי גבוה יותר של חמצן, ואילו בגבהים בהם לחץ החמצן נמוך יותר, יכולת הקישור שלו להמוגלובין נמוכה יותר.
אורגניזמים שונים הסתגלו לאתגר זה, וכך למשל מחקרים בעכברים "לבני רגליים" (deer mice), מצאו וריאנטים גנטיים שסייעו להסביר כיצד עכברים אלה מסוגלים לשרוד בהרים בגובה רב ובאוויר דל-חמצן. החוקר Reed מנברסקה פרסם בשנת 2009 ב-EBSCO Web, על מציאת מוטציות ב-4 גנים שונים בסוג עכברים זה, ששהו בגבהים בהשוואה לאותם עכברים שהעדיפו את מרחבי המישורים בגובה נמוך, ושהמוטציות התרחשו בגנים המפקחים על יכולת נשיאת החמצן על ידי ההמוגלובין בעכברים אלה, באופן שהעכברים השוהים בגבהים למדו לנצל טוב יותר את רמת החמצן הנמוכה בגבהים אלה.
ממצאים דומים התגלו בציפור יונק הדבש שמוצאים בהרי האנדים בדרום אמריקה. לציפור זו צרכים אנרגטיים מוגברים לחמצן, והמוטציות האמורות גרמו להמוגלובין שלהם להיות בעל זיקה מופחתת ל- inositol hexaphosphate או IHP, מולקולה שמוצאים בציפורים ואשר תפקידה דומה לזה של 2,3-BPG באדם, מה שמאפשר את היכולת לקשור חמצן בלחץ חלקי נמוך יותר ( Projecto-Garcia וחב' ב-Proc Natl Acad Sci USA משנת 2013). מולקולות כמו 2,3-BPG ו-IHP, מגיבות עם תת-יחידות β של המוגלובין נטול חמצן, על ידי שהן מפחיתות את הזיקה שלהן לחמצן, ועל ידי כך מסייעות באופן אלוסטרי לשחרור של מולקולות חמצן נותרות הקשורות להמוגלובין, ומשפרים את היכולת של האריתרוציטים לשחרר חמצן בסמוך לרקמות הזקוקות לו במיוחד.
יכולת ההסתגלות הזו הגיעה גם לאדם, ומחקרים הראו לדוגמה שמספר קטן של נשים טיבטיות היו בעלות גנוטיפ המקודד להמוגלובין בעל דרגת רווי גדולה יותר של חמצן. נראה שמנגנון ה"ברירה הטבעית" הוא הכוח המניע העיקרי להופעת המוטציות בגנים הרלוונטיים, שכן שיעור התמותה של צאצאי נשים טיבטיות אלו עם זיקה מוגברת של המוגלובין לחמצן, נמוך יותר בהשוואה לשיעור התמותה של צאצאי נשים טיבטיות עם זיקה נמוכה יותר של המוגלובין לחמצן.
מבנה ומנגנון הפעולה של המוגלובין
להמוגלובין מבנה רביעוני (quaternary) האופייני למספר גדול של חלבונים גלובולאריים עם מספר תת-יחידות. רוב חומצות האמינו בהמוגלובין יוצרות סלילוני α, המחוברים ביניהם על מקטעים לא-סלילוניים קצרים. קשרי מימן מייצבים את המבנים הסלילונים בתוך החלבון, ומסייעים לקיפול כל שרשרת פוליפפטידית להגיע למבנה המרחבי הספציפי לה (Steinberg ב- Disorders of Hemoglobin: Genetics, Pathophysiology, and Clinical Management. Cambridge University Press משנת 2001). המבנה הרביעוני של המוגלובין, מתקבל מארבע תת היחידות שלו בהתאמה טטרהדראלית.
לרוב בעלי החוליות מולקולת המוגלובין היא תצריף (assembly) של 4 תת-יחידות חלבוניות גלובולאריות. כל תת-יחידה מורכבת משרשרת חלבון הקשורה בחוזקה לגרעין heme, כאשר כל אחת מ-4 תת-יחידות אלו הזהות למעשה לחלבון מיוגלובין הנמצא בתאי שריר (Hardison ב-Proc Natl Acad Sci USA משנת 1996). מתווה התקפלות של תת-יחידות הגלובין יוצר מעין גומחה הקושרת בחוזקה את גרעין ה-heme, המורכב מיון ברזל האחוז בטבעת הטרוציקלית הידועה כפורפירין. טבעת הפורפירין בנויה מ-4 יחידות pyrrole, הקשורים באופן מעגלי על ידי קשרי methine, עם יון הברזל הקבוע במרכז. יון הברזל אליו נקשר החמצן, נמצא בקואורדינציה עם ארבעת אטומי החנקן במרכז הטבעת, כאשר כל חמשת האטומים האמורים נמצאים במישור אחד.
הברזל קשור בחוזקה בקשר קו-ולנטי לחלבון הגלובולארי דרך אטומי החנקן של טבעת ה-imidazole של שייר ה-F8 histidine (הידוע גם כהיסטידין הפרוקסימאלי) מתחת לטבעת הפורפירין. קיימת עמדה ששית שיכולה לקשור באופן הפיך חמצן על ידי קשר קו-ולנטי קואורדינטיבי, ובכך להשלים את הקבוצה האוקטהדראלית של ששה ליגנדים. חמצן נקשר באופן שאטום אחד שלו נקשר לברזל, והאטום השני בולט בזווית. כאשר חמצן אינו קשור, מולקולת מים תופסת את מקומו בקשר רופף יותר, על ידי יצירת octahedron מעוות. למרות שגם מולקולת דו-תחמוצת הפחמן (CO2) נישאת על ידי המוגלובין, היא אינה מתחרה עם חמצן הקישור לאתרי הקישור של ברזל, אלא נקשרת לשרשרות החלבון של המוגלובין.
הברזל יכול להיות או במצב של Fe+2 או של Fe+3, אך עמדת ferrihemoglobin (או Fe+3) הידועה גם כ-methemoglobin אינה יכולה לקשור חמצן (Linberg וחב' ב-Artif Cells Blood Substit Immobil Biotechnol משנת 1998). בהיקשר חמצן לברזל, הוא מחמצן אותו באופן ארעי והפיך מ-Fe+2 ל-Fe+3, בעוד שהחמצן עצמו הופך ליון superoxide, כך שהברזל חייב להיות קיים בשני מצבי החמצון על מנת לאפשר קישור חמצן. אם יון ה-superoxide הקשור ל-Fe+3 עובר פרוטונציה, ברזל ההמוגלובין יישאר מחומצן וחסר יכולת לקשור ברזל. במקרים אלה, האנזים methemoglobin reductase יהיה מסוגל בסופו של דבר לשפעל מחדש את methemoglobin על ידי החיזור של הברזל במרכז גרעין ה-heme.
כאשר כל ארבעת שיירי ה-heme קושרים O2, חלים שינויים במבנה של המוגלובין, שבאים לביטוי ביחס של הדימרים αβ, אחד כלפי השני. אחד מהדימרים הללו מסתובב בערך בשיעור של 18 מעלות עם תזוזה של 1 אנגסטרם ביחס לדימר השני.
כאשר המוגלובין נמצא בקונפיגורציה הקושרת O2, הידועה כ-R-state, הוא קושר חמצן בקלות, אך כאשר המוגלובין נמצא בקונפיגורציה בה חמצן אינו קשור לחלבון, הידועה כ-deoxy או כ-T-state, הוא אינו קושר חמצן בצורה טובה. הבדל זה ביכולת של המוגלובין לקשור חמצן בתלות בקונפיגורציה של המוגלובין, מכתיב את יכולתו לשאת חמצן לרקמות. בעת שהוא מעביר O2 חל שינוי מבני בהמוגלובין באופן שמונע ממנו לקשור יותר חמצן ומביא לשחרור האחרון לרקמות. כאשר כדוריות הדם האדומות חוזרות לריאות, ריכוז החמצן הגבוה בריאות גורם לקשירה מחדש של חמצן על ידי המוגלובין, שוב תוך כדי שינוי מבני של החלבון.
בבני אדם מבוגרים, צורת המוגלובין השכיחה ביותר היא טטרמר הידוע כhemoglobin A, המכיל שתי תת-יחידות אלפא (עם 141 חומצות אמינו) ושתי תת-יחידות β (עם 146 חומצות אמינו) הקשורות ביניהם בקשר לא קו-ולנטי. מבנה זה מוגדר כאמור כ- α2β2. תת יחידות אלה דומות במבנה שלהן וכמעט דומות בגודלן. כל תת-יחידה היא בעלת משקל מולקולארי של 16,000 דלטון בקירוב, עם משקל מולקולארי כולל של 64,458 דלטון (Van Beekvelt וחב' ב-J Appl Physiol משנת 2001). לכן, מקדם ההיפוך הוא 1gr/dL=0.1551 mmol/L. בתינוקות אדם, מולקולת המוגלובין מורכבת מ-2 שרשרות α, ו-2 שרשרות γ. שרשרות γ מתחלפות בהדרגה על ידי שרשרות β כאשר התינוק מתבגר. ארבעת השרשרות הפוליפפטידיות קשורות אחת לשנייה על ידי קשרי מלח, קשרי מימן וזיקה הידרופובית.
בהמוגלובין S (α2βS2) מתחולל שינוי בגן המקודד לשרשרת β, הגורם לשינוי בתכונות חלבון זה, וליצירת תאים חרמשיים. אנמיה חרמשית היא הפרעה אוטוזומלית (autosomal) נסגנית (recessive), בה נוצר המוגלובין S, כתוצאה מהחלפה נקודתית של טימין (Thimine) באדנין (Adenine) בגן לגלובין β. הדבר מביא להכנסת ואלין (Valine) במקום חומצה גלוטאמית (Glutamic acid) בשרשרת גלובין β. הנשאים ההטרוזיגוטים (Heterozygous) להמוגלובין S נקראים "Sickle cell trait". תאי דם חרמשיים הם בעלי אורך חיים קצר יותר מאשר תאי-דם תקינים. בגלל המבנה החרמשי שלהם, הם נוטים ל"היתקע" בכלי דם קטנים וצרים.
איפיון וריאנטים של המוגלובין
אלקטרופורזה של המוגלובין משמשת לסריקה וזיהוי של וריאנטים וסוגי המוגלובין לא תקינים. התהליך מתבצע על מצע אגר בסיסי ו/או ציטראט כאשר ההפרדה בין סוגי המוגלובין שונים מבוססת על מהירויות נדידה שונות של המוגלובינים טעונים חשמלית בשדה האלקטרופורטי. המוגלובין הוא טטרמר עם 2 זוגות של שרשרות גלובין, שכל אחד מהם מכיל גרעין heme זהה. המוגלובין נורמאלי של בוגרים (HbA) מכיל 2 שרשרות globin-α ו-2 שרשרות β-globin (או α2β2). המוגלובין עוברי (HbF) מכיל 2 שרשרות γ-globin או α2γ2. הפנוטיפ HbA2, או minor adult hemoglobin מורכב משתי שרשרות α-globin ושתי שרשרות δ-globin או α2δ2.
אלקטרופורזה של המוגלובין הוחלפה במרוצת השנים על ידי שיטות מהירות, רגישות וכמותיות יותר של הפרדת צורות המוגלובין השונות. אלקטרופורזה על מצע של צלולוז אצטאט ב-pH של 8.2-8.6, משמשת להפרדה בין וריאנטים כמו HbS ו-HbC, אך היא אינה יכולה להפריד בין HbS לבין HbDpunjab, או בין HbS לבין HbGPhiladelphia (ע"פ Chui ב-Hematology: Basic Principles and Practice. Edinburgh: Churchill Livingstone משנת 2008). אלקטרופורזה במצע אגר ציטראט ב-pH 6.0-6.2 מאפשרת הפרדה טובה יותר של וריאנטים שונים של המוגלובין (Schedlbauer & Pass ב-Pediatrics משנת 1989, ו-Robinson וחב' ב-J Lab Clin Med משנת 1957).
נוגדנים חד-שבטיים ממקור עכבר כנגד המוגלובין נורמאלי ווריאנטים שלו באדם, עשויים אף הם לשמש לזיהוי ו/או כימות של המוגלובינים, כגון מדידה של HbF בשיטת radial immunodiffusion או על ידי flow cytometry של אריתרוציטים המכילים HbF (ע"פ Dover ו-Boyer ב-Blood משנת 1987). טכנולוגיה אנליטית חדשה יותר, HPLC/electrospray mass spectrometry, יכולה לשמש לזיהוי המוגלובינים בלתי יציבים שיכולים לבוא לביטוי קליני כאנמיה או כתלסמיה ( Witkowska וחב' ב-Hemoglobin משנת 1993 וכן Caruso וחב' ב-Clin Lab Haematol משנת 2005 ו-Joutovsky וחב' ב-Clin Chem משנת 2004). שיטה נוספת, capillary electrophoresis, הוכיחה גם היא את יעילותה כשיטה אמינה ואכן נכנסת לאחרונה במעבדות קליניות רבות (Kim וחב' ב- Korean J Lab med משנת 2011).
הוריות לאלקטרופורזה של המוגלובין הן כדלקמן
- הערכה של אנמיה המוליטית בלתי מוסברת;
- אנמיה מיקרוציטית שלא על רקע חסר ברזל, מחלה כרונית או הרעלת עופרת;
- משטח דם עם מאפינים בלתי סדירים של אריתרוציטים (כגון תאים חרמשיים;
- סיפור משפחתי של המוגלובינופתיות;
- תוצאות חיוביות בסקירה נאונטלית.
- מבחן מסיסות בלתי תקין האופייני ל-HbS.
פיענוח של ממצאי אלקטרופורזה של המוגלובינים צריך להיעשות בצמידות להקשר הקליני, כולל סיפור משפחתי, ממצאי רמות ברזל בנסיוב, מורפולוגיה של אריתרוציטים, ומדדי רמות המוגלובין, המאטוקריט, ו-MCV.
בדיקת המוגלובין S יכולה להידרש אם מופיעים תסמינים שעלולים להיות רלוונטיים למחלת אנמיה חרמשית כגון: קוצר נשימה, גוון עור חיוור וטמפרטורת עור נמוכה בעיקר בגפיים, כאבי ראש או תחושת טשטוש, צהבת או גוון צהוב של העור ולובן העיניים.
משמעות התוצאה
- נוכחות של HbS, אך עם אחוז גבוה יותר של HbA מאשר של HbS: אופי של אנמיה חרמשית (HbAS) או של sickle α-thalassemia.
- נוכחות של HbS ושל HbF, אך לא של HbA: אנמיה חרמשית (HbSS), אנמיה חרמשית או β-תלסמיה או sickle beta 0 -thalassemia (נוכחות מורשת של המוגלובין עוברי [HPFH]).
- יחס גבוה יותר של HbS על פני HbA ו-HbF: סבירות גבוהה יותר של Sickle β + -thalassemia.
- נוכחות של HbC, אך עם יחס גבוה יותר של HbA מאשר HbC: אופי של HbC או HbAC.
- נוכחות של HbC ו-HbF, אך ללא HbA: מחלת HbC או HbCC, או beta- HbC 0 -(HbC-HPFH) thalassemia .
- יחס גבוה יותר של HbC מאשר של HbA פירושו : HbC β + -thalassemia.
- נוכחות של HbS ו-HbF,: מחלת HbSC.
- נוכחות של HbH: מחלת HbH.
- נוכחות מוגברת של HbA2: מחלת Beta-thalassemia minor.
- נוכחות מוגברת של HbF יכולה להופיע ב- Hereditary persistence of fetal hemoglobin, sickle cell anemia β-thalassemia, HbC disease, HbE disease.
מגבלות שיטת הבדיקה
תוצאות חיוביות-כזובות (false positive) יכולות להתקבל כתוצאה ממספר גדול יחסית של תאי דם אדומים מגורענים. תוצאות שליליות-כזובות יכולות להתקבל במקרים של תינוקות עם ריכוז HbS נמוך מדי, או כתוצאה מעירוי דם שניתן בסמוך לבדיקה. ריכוזי Hb של 15-20% יכולים גם כן לתת תוצאות שליליות.
אין בפרוצדורה זו כדי להבדיל בין המצב ההטרוזיגוטי של המוגלובין S לבין המצב ההומוזיגוטי של מחלת sickle cell, וכן אין בשיטה כדי להבדיל בין הצירופים הבאים: S/C; S/D; S/G; S/E; S/thalassemia; S-O-Arab; S/New-York ו-C-Georgetown trait (Hb C-Harlem). השימוש בכדוריות דם אדומות דחוסות במקום דם מלא מפחית באופן משמעותי תוצאות שליליות כזובות (false negatives) שיכולות להיגרם כתוצאה מאנמיה, או תוצאות חיוביות-כזובות (false positives) כתוצאה מ- hyper-gammaglobulinemia במקרה של מיאלומה נפוצה. תוצאות false-positive עלולות להופיע במקרים עם של מספר גדול יחסית של תאי דם מגורענים.
הוראות לביצוע הבדיקה
אין צורך בשום הכנות או צעדים מיוחדים לפני הבדיקה. רצוי שדגימת דם מלא תילקח במבחנת ספירת דם (EDTA, פקק סגלגל), אם כי גם מבחנת הפארין (פקק ירוק) או מבחנת ציטראט (פקק תכול) יכולות להתקבל. סיבות לפסילת הדגימה: פלזמה מאוד המוליטית. המוליזה קלה, כמו גם דגימה ליפמית או איקטרית אינם מפריעים לביצוע הבדיקה. יש לשמור את הדם המלא במבחנת ספירת הדם בקירור עד 7 ימים. ביצוע בדיקה זו בסמוך לעירוי דם, עלול לא לשקף את הרמה האמיתית של HbS. בילדים בגיל הרך יש השפעה לגיל הנבדק. תינוקות מתחת גיל 3 חודשים, צריכים לחזור על הבדיקה בסביבות גיל 6 חודשים.
ראו גם
המידע שבדף זה נכתב על ידי פרופ' בן-עמי סלע, המכון לכימיה פתולוגית, מרכז רפואי שיבא, תל-שומר;
החוג לגנטיקה מולקולארית וביוכימיה, פקולטה לרפואה, אוניברסיטת תל-אביב (יוצר הערך)


 כניסה
כניסה  עקבו אחרינו בפייסבוק
עקבו אחרינו בפייסבוק 



